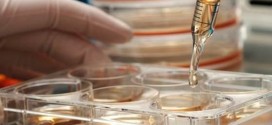
PTC drug wins EU panel vote, Report

The fight to keep zebra mussels out of Lake Winnipeg begins today with the deployment of a rubber curtain designed to keep thousands of gallons of potash solution in Winnipeg Beach harbour.
Read More »News
Louis LeBel : Supreme Court Justice from Quebec announces retirement
Prime Minister Stephen Harper will have another opportunity to put his stamp on the country’s most influential court now that Supreme Court Justice Louis LeBel of Quebec has announced he will leave on Nov. 30, his 75th birthday, when his retirement is mandatory.
Read More »Wet Hot American Summer Prequel Series Headed For Netflix, Report
A prequel to the 2001 satirical comedy film “Wet Hot American Summer” might be coming to the small screen soon, courtesy of Netflix. Multiple sources told Variety that the David Wain and Michael Showalter-created film might be having a 10-episode prequel from the streaming service that is currently widening its lineup of original programming.
Read More »Merry Pranksters : Ken Kesey’s son aims for 50th anniversary Further bus tour
When the late author Ken Kesey and his pals, the Merry Pranksters, took their psychedelic bus ride across America to visit the New York World’s Fair, the nation was mourning President John F Kennedy’s assassination and the Grateful Dead were not yet a band. And, perhaps most importantly, LSD was still legal. For their trip, they rode in a bus …
Read More »Beyonce, Jay Z skip Kimye Wedding For Hamptons Weekend
Well, it’s official. Beyonce and Jay Z decided not to attend Kim Kardashian and Kanye West’s wedding in Florence, Italy. Instead, they opted for a beach weekend in New York. But why? Beyonce, 32, and Jay Z, 44, were not in attendance as Kim Kardashian, 33, and Kanye West, 36 professed their undying love to each other on Saturday, May …
Read More »PTC drug wins EU panel vote, Report
PTC Therapeutics Inc. announced that following its request for re-examination, the Committee for Medicinal Products for Human Use (CHMP) of the European Medicines Agency (EMA) has adopted a positive opinion regarding the company’s application for a conditional marketing authorization of Translarna (ataluren) for the treatment of nonsense mutation Duchenne muscular dystrophy (nmDMD) in ambulatory patients aged five years and older.
Read More »Santa Barbara Shooting : Gunman kills seven in drive-by shooting in California college town
At least seven people were killed, and seven more were wounded in a string of shootings carried out by a lone gunman on Friday night, Santa Barbara County Sheriff Bill Brown confirmed at a news conference this morning. The gunman, who investigators believe acted alone, drove a black BMW through the Isla Vista neighborhood, a student enclave located near the …
Read More »Killing of three daughters : Mom could face death penalty
Murder charges filed against a West Carson mother accused of killing her three young daughters carries a special allegation that could bring the death penalty, prosecutors said. But the Los Angeles County district attorney’s office said Friday it would decide later whether to seek the death penalty against Carol Coronado, 30.
Read More »Apple iPhone 6 is coming : Survey Shows What iFans Desire Most
Expected to be announced soon, the iPhone 6 is being rumored as a bigger, badder version of the iPhone we’ve all come to know. A recent survey aimed to ask users what they wanted from the new device, and the results were generally in line with what the rumors are. There are, however, some things we want that may not …
Read More »Houston Zoo Opens New “exotic bugs House”
Zoo employees at the Houston Zoo’s new bug house get their first look at the exhibits Friday, May 23, 2014, in Houston. The Bug House, opening this weekend, has 30 species of native and exotic insects on display.
Read More »Target Reports 16% Drop in Earnings, Report
Target Corp.’s profit fell 16% as the retailer ramped up discounts to win shoppers back after its massive data breach and as losses mounted at its Canadian operation, highlighting the depths of the challenges that forced out Chief Executive Gregg Steinhafel earlier this month.
Read More » Canada Journal – News of the World Articles and videos to bring you the biggest Canadian news stories from across the country every day
Canada Journal – News of the World Articles and videos to bring you the biggest Canadian news stories from across the country every day